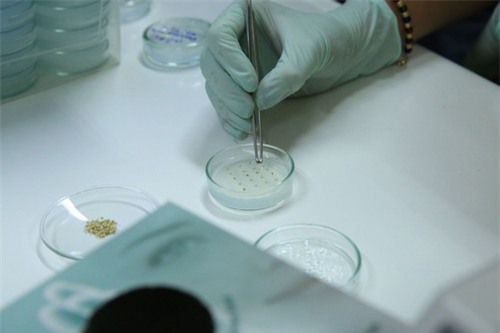
Khám phá hầm lưu trữ hàng triệu giống cây nằm sâu dưới lòng đất - 9

Hầm lưu trữ Svalbard thuộc khu vực Svalbard và Jan Mayen của Na Uy, một nơi nhân tạo có sự đa dạng sinh học cao nhất trên thế giới. Nơi đây bảo tồn và phát triển đến 4,5 triệu mẫu cây trồng từ khắp nơi trên thế giới. Ảnh: GCDT.

Hầm được chôn sâu trong lòng đất, tại đúng nơi vòng cực bắc cắt ngang qua thuộc lãnh thổ của Na Uy. Ảnh: GCDT.

Hầm chứa được mở cửa vào năm 2008, được tạo ra sau khi cho khoan và nổ mìn những tảng đá sa thạch và đá sét của núi Platåberget, phía nam vịnh Advent Fjord. Ảnh: GCDT.

Căn hầm này rất rộng lớn với những dãy hành lang trải dài và các phòng chứa to lớn. Hình: GCDT.

Hầm chứa này là một dự án chuẩn bị cho ngày tận thế nếu ngày này thật sự xảy ra, những hạt giống được bảo tồn sẽ được trồng lại trên khắp thế giới. Ngoài ra, nó cũng là nơi dự trữ các giống cây nếu chẳng may loài đó bị biến mất ở bên ngoài môi trường. Ảnh: GCDT.

Vì nằm sâu bên dưới lòng đất tại vùng khí hậu lạnh giá, được bao phủ xung quanh bằng các lớp băng vĩnh cửu, nơi đây hầu như không thể bị phá hủy và luôn duy trì được độ lạnh dù cho nguồn điện bị sập. Ảnh: GCDT.

Những kệ kim loại lưu trữ các giống cây luôn duy trì ở nhiệt độ -18 độ C. Mỗi kệ rộng 65 cm, dài 125 cm và cao 300 cm. Ảnh: GCDT.

Cửa hầm hướng ra vịnh biển Advent Fjord, nơi quanh năm hầu như đều lạnh lẽo và có băng tuyết phủ dày. Ảnh: GCDT.
Những hạt giống được lưu trữ có thể tồn tại đến hàng trăm hay thậm chí là hàng ngàn năm mà không bị chết đi hoặc mất khả năng nảy mầm. Ảnh: GCDT.

Tất cả các hạt giống thực vật trên khắp thế giới, từ ôn đới đến nhiệt đới, đều được bảo quản kỹ lưỡng đến hàng thế kỷ. Ảnh: GCDT.

Ở những khu vực bảo quản các giống cây ôn đới, các phòng đều có các bức tường bằng băng tuyết tự nhiên, đảm bảo độ lạnh cho nơi bảo quản. Ảnh: GCDT.